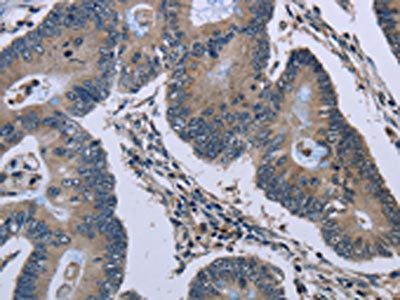

-
中文名稱:GJC2兔多克隆抗體
-
貨號:CSB-PA065045
-
規格:¥1100
-
圖片:
-
The image on the left is immunohistochemistry of paraffin-embedded Human colon cancer tissue using CSB-PA065045(GJC2 Antibody) at dilution 1/40, on the right is treated with synthetic peptide. (Original magnification: ×200)
-
The image on the left is immunohistochemistry of paraffin-embedded Human thyroid cancer tissue using CSB-PA065045(GJC2 Antibody) at dilution 1/40, on the right is treated with synthetic peptide. (Original magnification: ×200)
-
-
其他:
產品詳情
-
Uniprot No.:
-
基因名:GJC2
-
別名:GJC2; GJA12; Gap junction gamma-2 protein; Connexin-46.6; Cx46.6; Connexin-47; Cx47; Gap junction alpha-12 protein
-
宿主:Rabbit
-
反應種屬:Human,Mouse,Rat
-
免疫原:Synthetic peptide of Human GJC2
-
免疫原種屬:Homo sapiens (Human)
-
標記方式:Non-conjugated
-
抗體亞型:IgG
-
純化方式:Antigen affinity purification
-
濃度:It differs from different batches. Please contact us to confirm it.
-
保存緩沖液:-20°C, pH7.4 PBS, 0.05% NaN3, 40% Glycerol
-
產品提供形式:Liquid
-
應用范圍:ELISA,IHC
-
推薦稀釋比:
Application Recommended Dilution ELISA 1:2000-1:5000 IHC 1:50-1:200 -
Protocols:
-
儲存條件:Upon receipt, store at -20°C or -80°C. Avoid repeated freeze.
-
貨期:Basically, we can dispatch the products out in 1-3 working days after receiving your orders. Delivery time maybe differs from different purchasing way or location, please kindly consult your local distributors for specific delivery time.
-
用途:For Research Use Only. Not for use in diagnostic or therapeutic procedures.
相關產品
靶點詳情
-
功能:One gap junction consists of a cluster of closely packed pairs of transmembrane channels, the connexons, through which materials of low MW diffuse from one cell to a neighboring cell. May play a role in myelination in central and peripheral nervous systems.
-
基因功能參考文獻:
- Different mutations in the Cx47 lead to discrepant activation of unfolded protein response (UPR) pathway, which encouraged apoptotic cell death at different levels. Inappropriate activation of UPR may play important roles in the pathophysiology of Pelizaeus-Merzbacher-Like Disease. PMID: 28712094
- GJC2 promoter region mutation screening should be included in the evaluation of patients with unexplained hypomyelinating leukodystrophies. PMID: 24374284
- we provide evidence that a mutation in GJA1 leads not only to ODD as already described in the literature, but can also lead to lymphoedema as an associated feature. PMID: 23550541
- a novel homozygous mutation in GJC2 was identified in a 21-year-old female patient with Pelizaeus-Merzbacher-like disease PMID: 23684670
- This study identified novel chromosomal rearrangements proximal and distal to, and exclusive of the PLP1 gene, showed equal frequencies of PLP1 and GJA12/GJC2 mutations PMID: 22283455
- Most of the Pelizaeus-Merzbacher-like disease (PMLD)-linked Cx47 mutants disrupt Cx47/Cx47 and Cx47/Cx43 GJ function in the glial network, which may play a role in leading to PMLD symptoms PMID: 23544880
- the extremely severe clinical Pelizaeus-Merzbacher-like disease form likely correlates with the predicted impairment of gap junction channel assembly resulting from the detrimental effect of the new p.Glu260Lys mutant allele on Cx47 protein PMID: 22669416
- founder mutation c.-167A>G localized in the GJC2 protein promoter region in patients with Pelizaeus Merzbacher disease and Pelizaeus Merzbacher like disease PMID: 23142375
- Cx47 mutations were identified in individuals having secondary lymphedema following breast cancer treatment; these novel mutations are dysfunctional and provide evidence that altered gap junction function leads to lymphedema PMID: 22351697
- We report the identification of the GJC2 promoter mutation (c.-167A>G) in nine patients from three unrelated Pakistani families with Pelizaeus-Merzbacher-like disease. Linkage analysis was consistent with a likely founder effect of this mutation PMID: 21959080
- Mutations within the GJC2 gene are associated with primary lymphoedema. PMID: 21266381
- The identification of GJC2 mutations as a cause of primary lymphedema PMID: 20537300
- GJA12 gene mutations reported from two Chinese Pelizaeus-Merzbacher-like disease patients PMID: 19423250
- She carried no GJA12 mutations. These facts suggested that this disease is a novel, autosomal recessive hypomyelinating leukodystrophy. PMID: 20120347
- Patients from one family carrying a homozygous frameshift mutation in GJA12 presenting with nystagmus and brain demyelinating disease. PMID: 16969684
- GJA12 mutations are the initiaial genetic test in patients with consanguineous parents with Pelizaeus-Merzbacher-like disease. PMID: 17031678
- study shows the Cx47 mutants associated with Pelizaeus-Merzbacher-like disease likely disrupt the gap junction coupling between astrocytes and oligodendrocytes PMID: 17344063
- The clinical phenotype of patients with a GJA12 mutation was evaluated and is overall comparable to the clinical features seen in mild forms of PLP1-related disorder but with better cognition and earlier signs of axonal degeneration. PMID: 18094336
- GJA12 alterations are a rare cause of Pelizaeus-Merzbacher-like disease even after extending the screening for copy number variation and for mutations in the non-coding region of GJA12. PMID: 18521858
- GJA12/GJC2 mutations can result in a milder phenotype than previously appreciated, but whether I33M retains a function of Cx47 not directly related to forming functional gap junction channels is not known. PMID: 19056803
顯示更多
收起更多
-
相關疾病:Leukodystrophy, hypomyelinating, 2 (HLD2); Spastic paraplegia 44, autosomal recessive (SPG44); Lymphedema, hereditary, 1C (LMPH1C)
-
亞細胞定位:Cell membrane; Multi-pass membrane protein. Cell junction, gap junction.
-
蛋白家族:Connexin family, Gamma-type subfamily
-
組織特異性:Expressed in central nervous system, in sciatic nerve and sural nerve. Also detected in skeletal muscles.
-
數據庫鏈接:
Most popular with customers
-
-
YWHAB Recombinant Monoclonal Antibody
Applications: ELISA, WB, IHC, IF, FC
Species Reactivity: Human, Mouse, Rat
-
Phospho-YAP1 (S127) Recombinant Monoclonal Antibody
Applications: ELISA, WB, IHC
Species Reactivity: Human
-
-
-
-
-